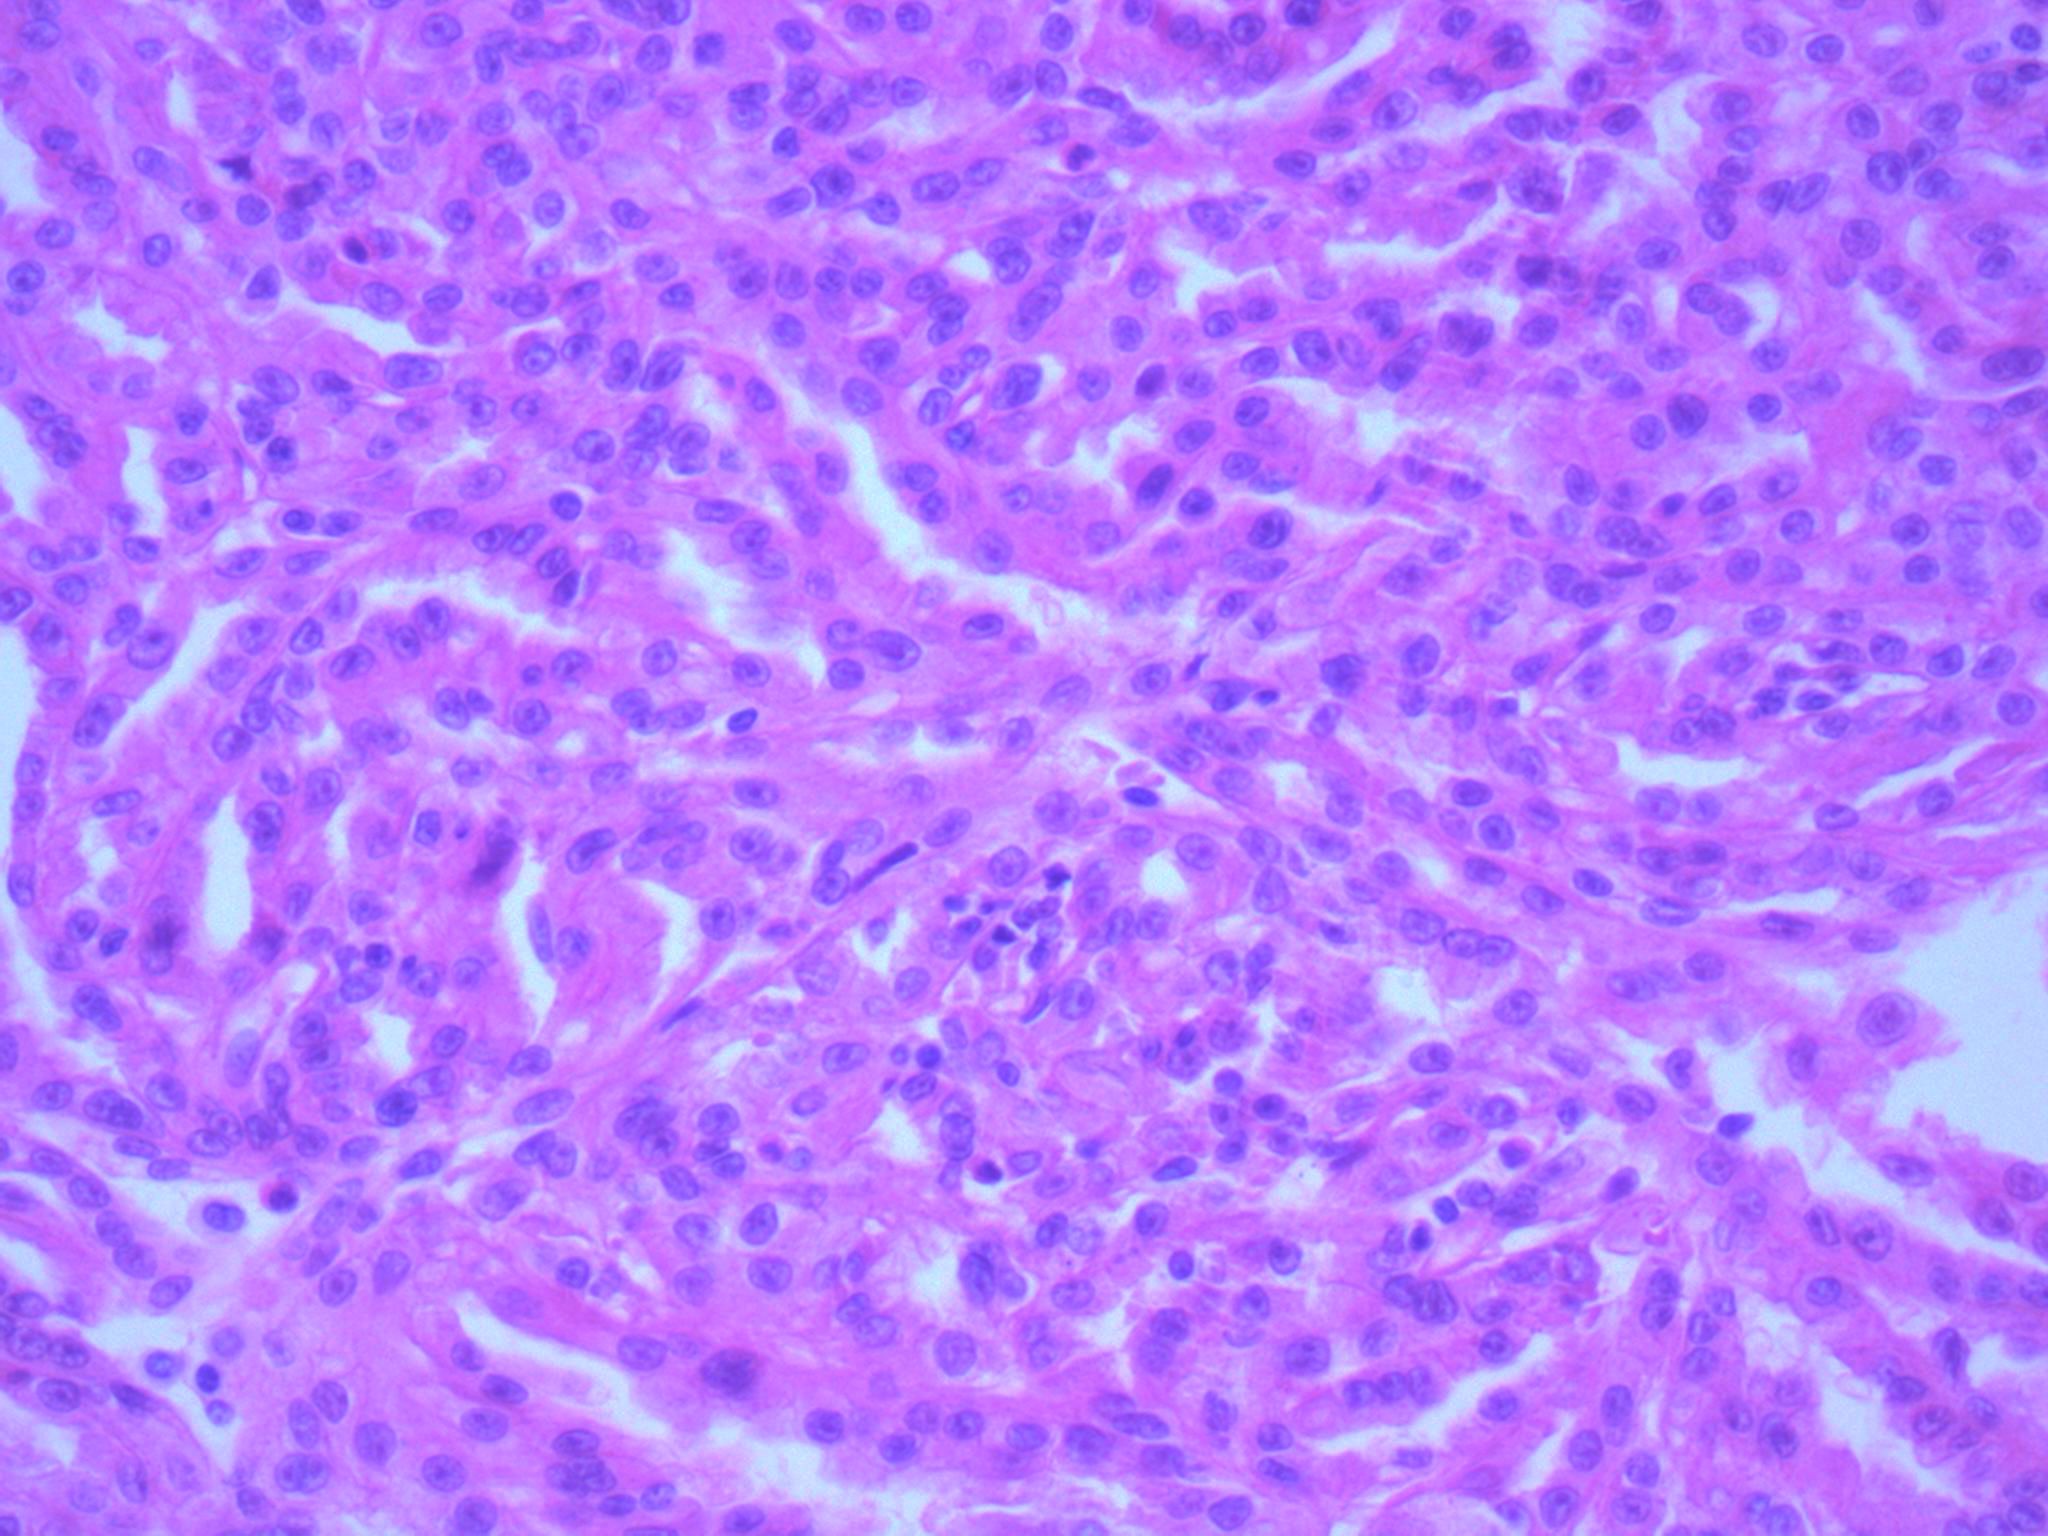
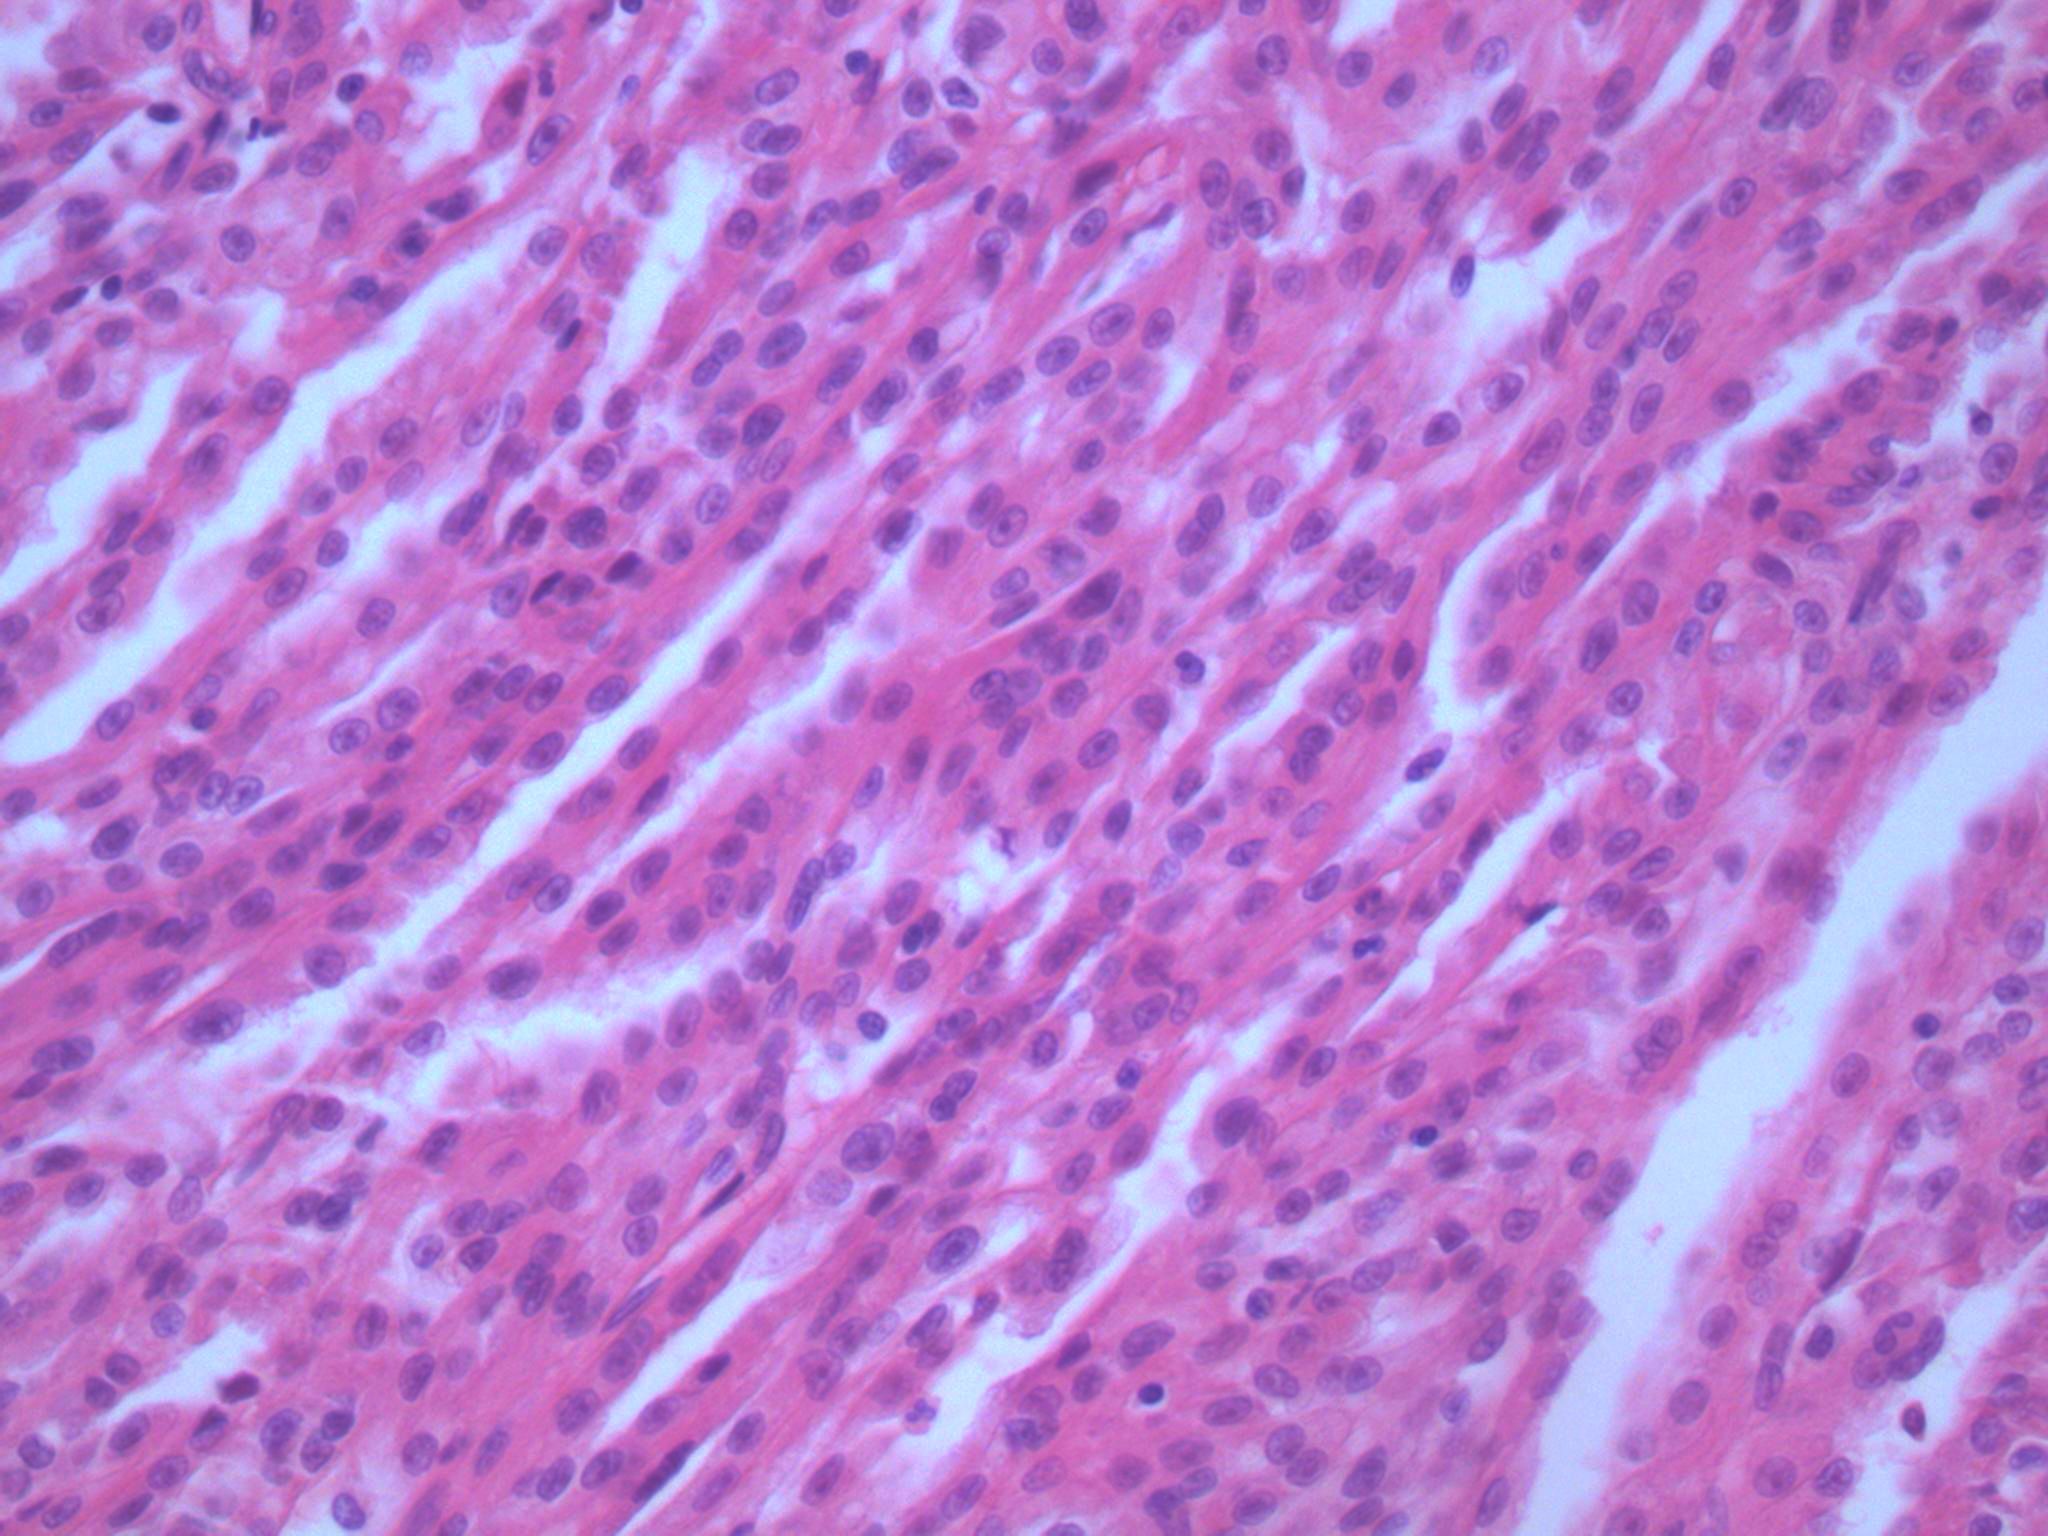
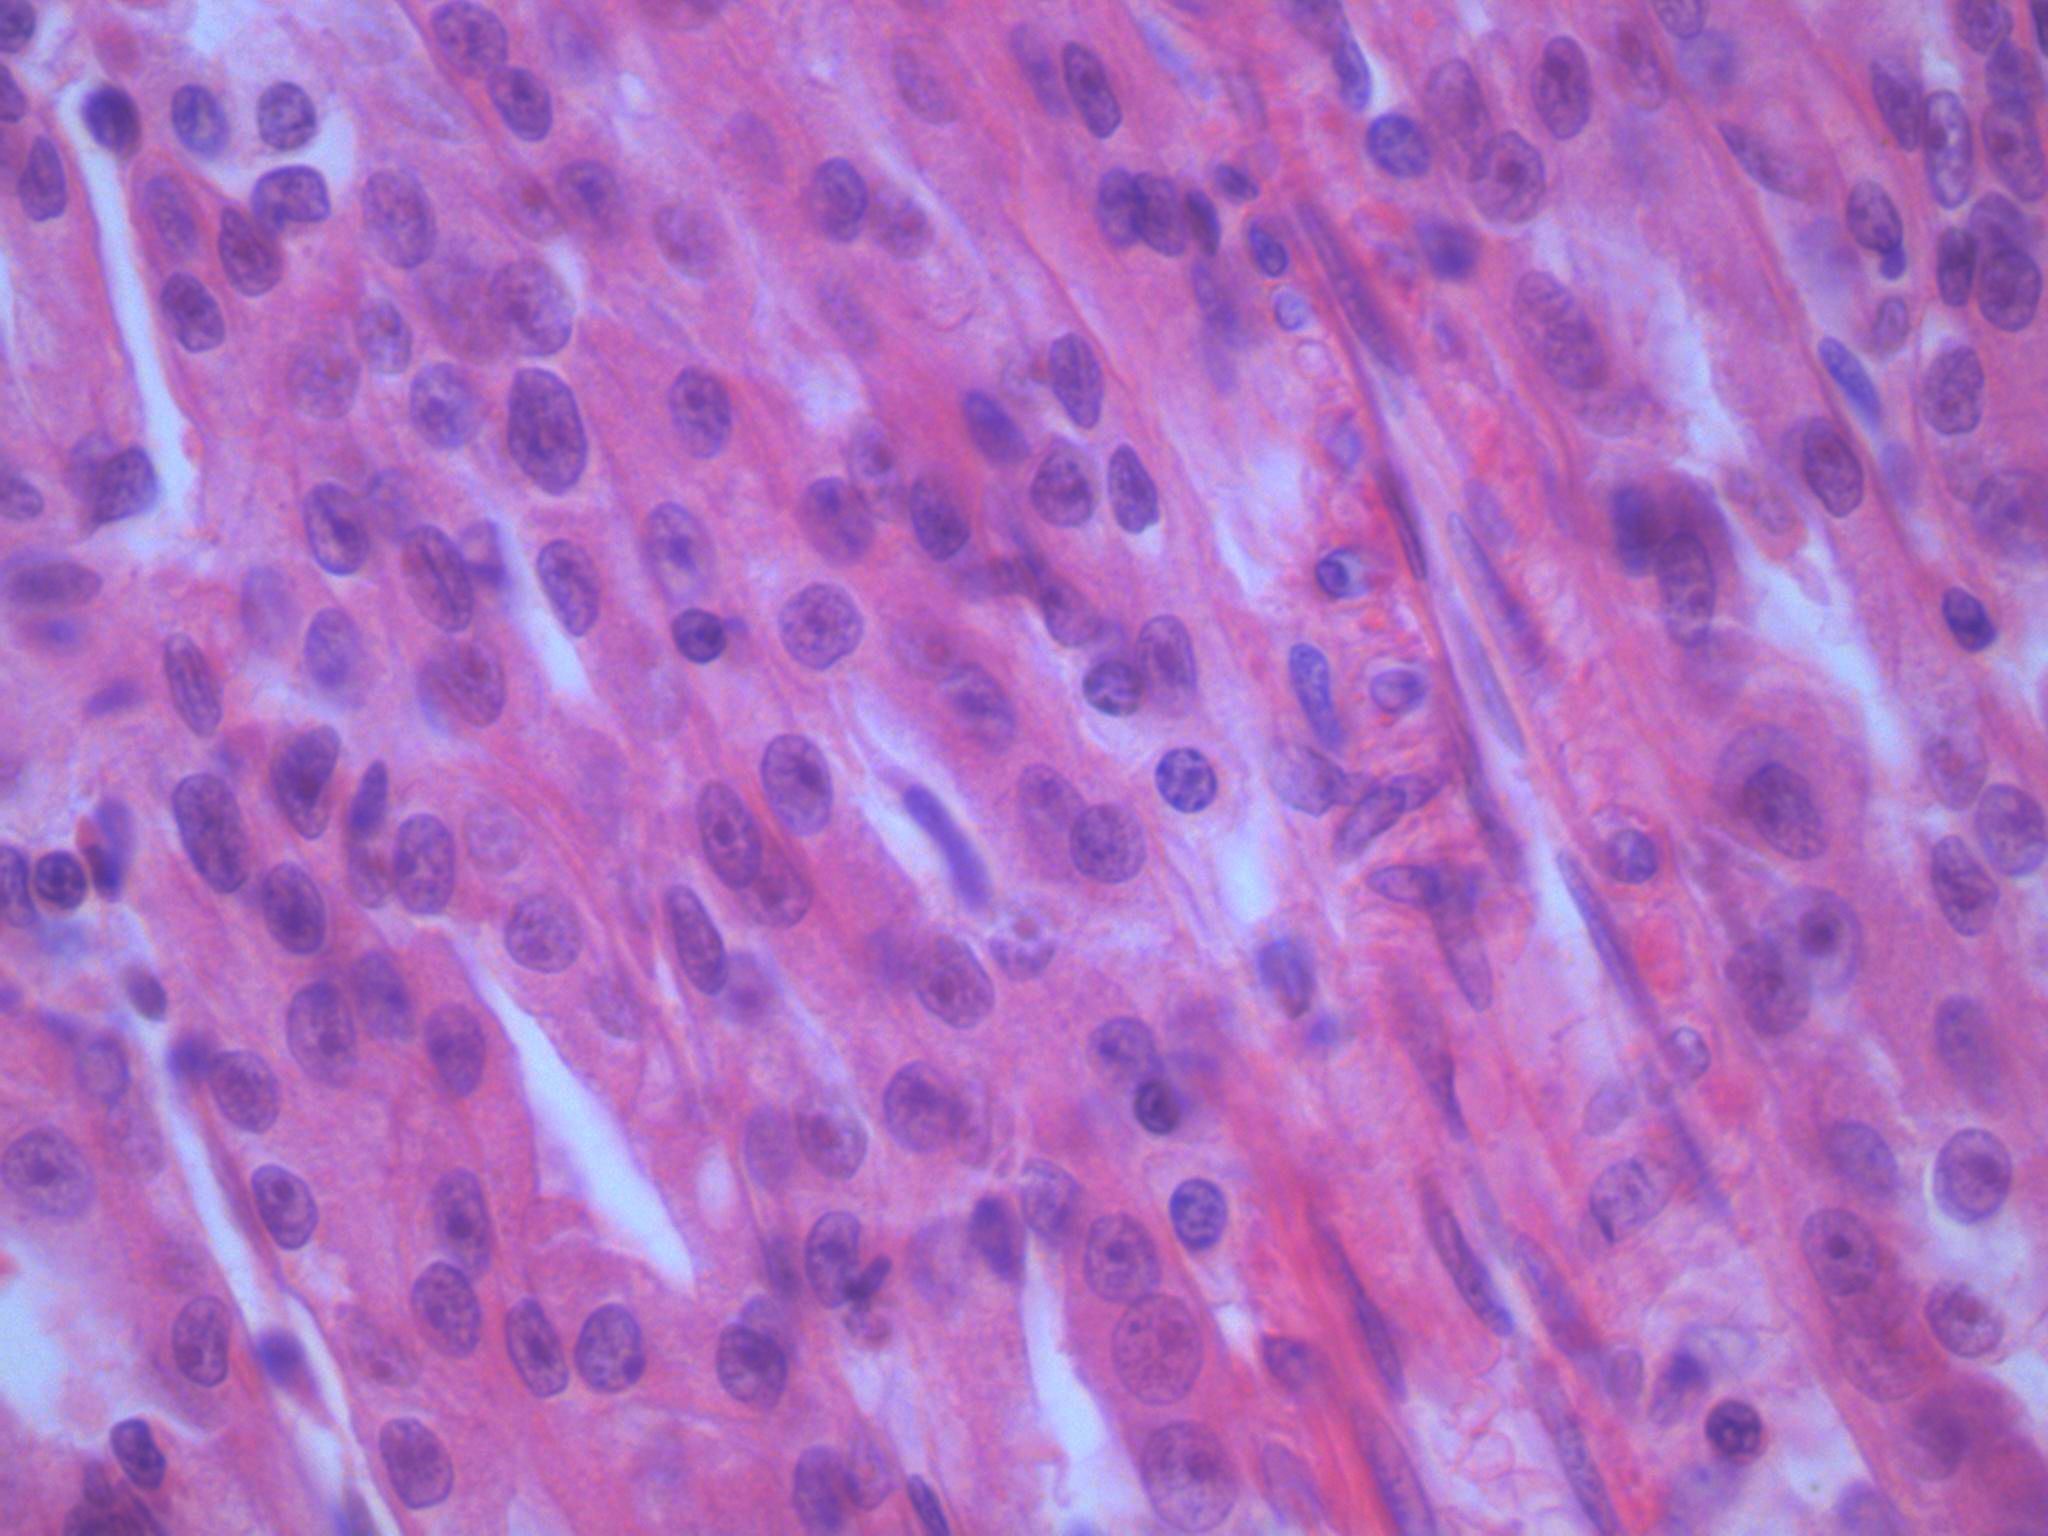

Case ID: 1036
Publication date: 22 Jan, 2016
Consensus grade: Mucinous tubular and spindle cell carcinoma
Show diagnosis by expert panel members| User | Diagnosis | Difficulty | Comment |
|---|---|---|---|
| Pathologist 1 | Mucinous tubular and spindle cell carcinoma | Typical | |
| Pathologist 2 | Mucinous tubular and spindle cell carcinoma | Not typical | |
| Pathologist 3 | Mucinous tubular and spindle cell carcinoma | Typical | |
| Pathologist 4 | Mucinous tubular and spindle cell carcinoma | Typical | |
| Pathologist 5 | Mucinous tubular and spindle cell carcinoma | Not typical | |
| Pathologist 6 | Mucinous tubular and spindle cell carcinoma | Typical |
differentail papillary type I? |
| Pathologist 7 | Mucinous tubular and spindle cell carcinoma | Typical | |
| Pathologist 8 | Renal cell carcinoma, unclassified | Not typical |
Pap vs mtscc |
| Pathologist 9 | Papillary RCC (Type 1) | Typical | |
| Pathologist 10 | Mucinous tubular and spindle cell carcinoma | Typical | |
| Pathologist 11 | Mucinous tubular and spindle cell carcinoma | Typical | |
| Pathologist 12 | Mucinous tubular and spindle cell carcinoma | Typical | |
| Pathologist 13 | Mucinous tubular and spindle cell carcinoma | Typical | |
| Pathologist 14 | Mucinous tubular and spindle cell carcinoma | Not typical |
In such cases I always try to rule out PRCC NOS......FISH for chromosomes 7,17 can be helpfull. |
| Pathologist 15 | Mucinous tubular and spindle cell carcinoma | Typical | |
| Pathologist 16 | Mucinous tubular and spindle cell carcinoma | Typical | |
| Pathologist 17 | Mucinous tubular and spindle cell carcinoma | Typical |
need lower mag images |
| Pathologist 18 | Papillary RCC (Type 1) | Not typical |
not spindled enough for mucinous tubular spindle cell carcinoma |
| Pathologist 19 | Mucinous tubular and spindle cell carcinoma | Typical |
Case description (by case creator):
Tumour composed of elongated clefts and tubules